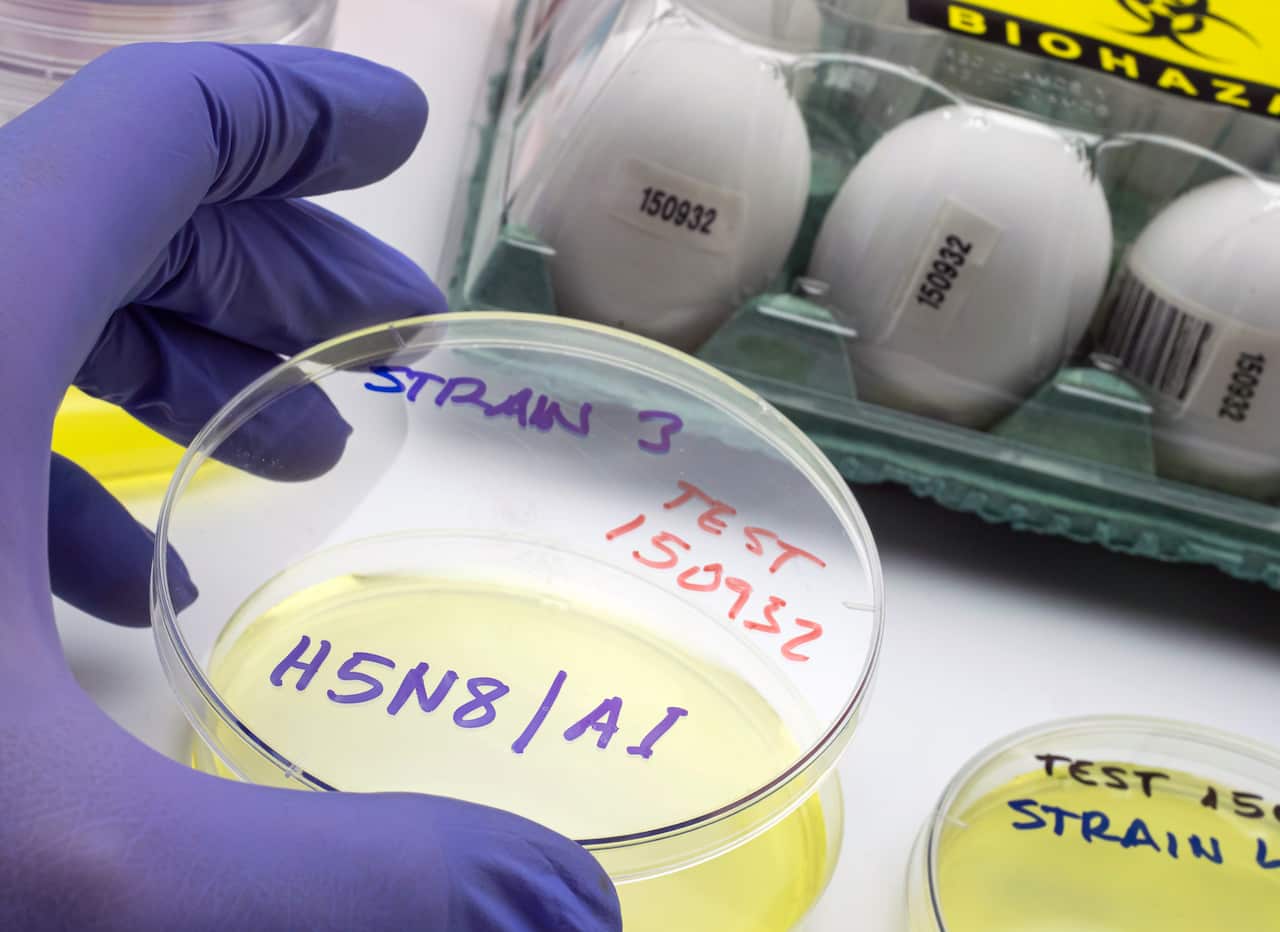
A hand wearing a blue clinical glove holds a petri dish containing bird flu samples.

Following the first human death from the H5N5 strain of bird flu, experts are warning the virus, of which a number of strains are circulating in parts of the world, could lead to the world's next pandemic.
The death also comes as bird flu was detected in an Australian external territory for the first time.
European health authorities warned this month that governments should step up efforts to combat bird flu threats amid an "unprecedented" number of outbreaks in the northern hemisphere's autumn.
Since September, more than 1,400 infections among wild birds and poultry have been detected in at least 26 European countries, four times higher than a year ago and the highest level since 2016, raising the risk that the virus could spill over into people, according to the European Centre for Disease Prevention and Control (ECDC).
Some forms of bird flu, like H5N1, have a higher mortality rate in humans than COVID-19, although infections are rare and typically occur in cases who have been in close contact with sick birds and livestock.
News that makes sense
Your trusted source for staying up-to-date with the world around you. Get free daily news updates and analysis, straight to your inbox.
Some experts say it's becoming more likely that the bird flu virus could become the next pandemic, while others agree its possible but say the probability is "very low".
What do we know about bird flu pathogens?
Professor Adrian Esterman, an epidemiologist and biostatistician from the University of South Australia, said H5N5, like the first strain detected in humans in Hong Kong in 1997, H5N1, was highly infectious.
"The one that's really causing worry at the moment is the H5N1, which is going around the world, not only killing off millions of wild birds and domestic birds, but it's also affecting mammals all around the world," he told SBS News.
"These are all what we call highly pathogenic avian flu, basically, there's two types of bird flu, there's bird flu, which is quite mild and basically doesn't kill off the wild birds, which is called low pathogenic avian flu, then there's highly pathogenic, and both H5N5 and H5N1 are highly pathogenic," Esterman said.
Since the early Hong Kong human transmission cases, there have been more than a dozen strains, with cases flaring in different parts of the world at different times.
There are almost 1,000 recorded cases of the H5 strains being transmitted to humans, with at least 476 human deaths recorded since 2003.
The United States Centers for Disease Control and Prevention recorded 11 deaths from bird flu between January and August; these were in Cambodia, India and Mexico.
A changing virus
Esterman said like the coronavirus, the avian flu virus continued to morph.
"The H and the N stand for proteins that spike out from the flu," he said.
"What happens is, every year they tend to change a little bit, and every few years they have a major change."
Outbreaks of other strains, including H7 subtypes, have occurred on poultry farms in some eastern states in recent years and have been eradicated.
Scientists came across H5N5 in animals around 2008.
The first known human case of the variant was identified in the US this year and the man, who had underlying health conditions, died in November.
One case does not provide a full picture of the risk a variant poses, but Esterman said the fact that H5N1 had such a high mortality rate for humans, about 48 per cent, meant any spread of avian flu variants to humans was "a big worry".
In November, the federal government confirmed the H5N1 strain had been detected for the first time on remote Heard Island, 4,000km south-west of Perth and 1,700km north of Antarctica.
How humans catch bird flu
Most of the recent cases of bird flu have been in the US.
Esterman said bird flu had been passed on from animals to humans through physical contact with the virus.
While the virus is also in wild birds, humans most often catch it from either domestic birds or from cattle and dairy cows.
"Usually it's a dead animal, and you know, they'll touch a dead animal, but I suppose they can pick it up from just droppings on the ground," he said.
Esterman said most of the people who contracted the virus either worked in the dairy or poultry industries or were associated with them.
He said while it was possible for the virus to be passed from human to human, there was little to no evidence of its spread that way.

Professor Paul Griffin, an infectious diseases physician from the University of Queensland's medical school, said avian flu could result in chest infections, coughing, breathing difficulties and even respiratory failure.
Avian flu could arrive in Australia
Cassandra Berry, a professor of immunology at Murdoch University, said the eventual arrival of H5 variants of bird flu into Australia was inevitable.
"We are now surrounded by the virus," she said.
"Australia and Antarctica were the only continents free of bird flu in the world, but that changed a few years ago, with virus outbreaks being observed in Antarctica and surrounding islands.
"Even the expedition leaders on my recent trip to the Antarctic peninsula earlier this year remarked on the low sightings of crab-eater seals and skuas, likely decimated by a highly pathogenic bird flu strain."
Berry said if the virus jumped into animal species in Australia, culling and ring vaccination, in which populations of animals surrounding the confirmed cases were vaccinated, would be the preferred control measures.
"However, neighbouring countries have been mass vaccinating their poultry to protect flocks, industry and food supply," she said.
"In the meantime, virus surveillance is the key biosecurity measure."
The next potential pandemic
Berry, Griffin and Esterman all agreed there was potential for the bird flu to become a pandemic.
"A pandemic is always on the cards," Berry said.
Esterman said one reason the H5 strains pose such a risk to humans is that "it's got such a high mortality rate".
"All the people who've been infected with the H5N1 strain over the last 20 years, half of them have died, so it's nasty," he said.
The mortality rate from H5N1 is about 48 per cent, which is much higher than the nearly 3 per cent mortality rate of COVID-19.
Griffin said while there were a lot of variables to consider, if bird flu started spreading between humans, he estimated it'd take just days to "really spread all around the world".
He said the fact "we're not seeing very many human cases, and seeing very rare, if any, human-to-human spread of these, so at the moment," was reassuring.
However, he said a growing number of bird species and other animals were becoming affected and the virus was increasing its geographical spread.
"So it has the makings for a potentially significant situation, if that ability to be transmitted to and between humans increases," Griffin said.
He said monitoring animal populations was vital.
"We need to be monitoring for the potential changes that might give these flus the ability to be more transmissible in humans, and we need to, you know, make sure that surveillance continues, but also that we're preparing for if it does make its way into humans, for how we'd respond to that," Griffin said.
He said while there was a vaccine for H5N1, there was not currently a vaccine for H5N5.
"With vaccine technology more broadly, we are in a fortunate position that we can adapt our vaccines potentially more quickly, but flu vaccines and the traditional platform do take quite a bit of time to manufacture," he said.
Gregorio Torres, head of the Science Department at the World Organisation for Animal Health, told the Reuters news agency the risk of a human pandemic developing from the bird flu virus remains low,.
"We need to be prepared to respond early enough. But for the time being, you can happily walk in the forest, eat chicken and eggs and enjoy your life," he said. "The pandemic risk is a possibility. But in terms of probability, it's still very low."
The government committed an additional $95 million to both protecting Australia from and preparing the country for the outbreak of bird flu in October 2024.
The funding has gone towards strengthening national biosecurity response capability, surveillance and public health preparedness.
For the latest from SBS News, download our app and subscribe to our newsletter.

